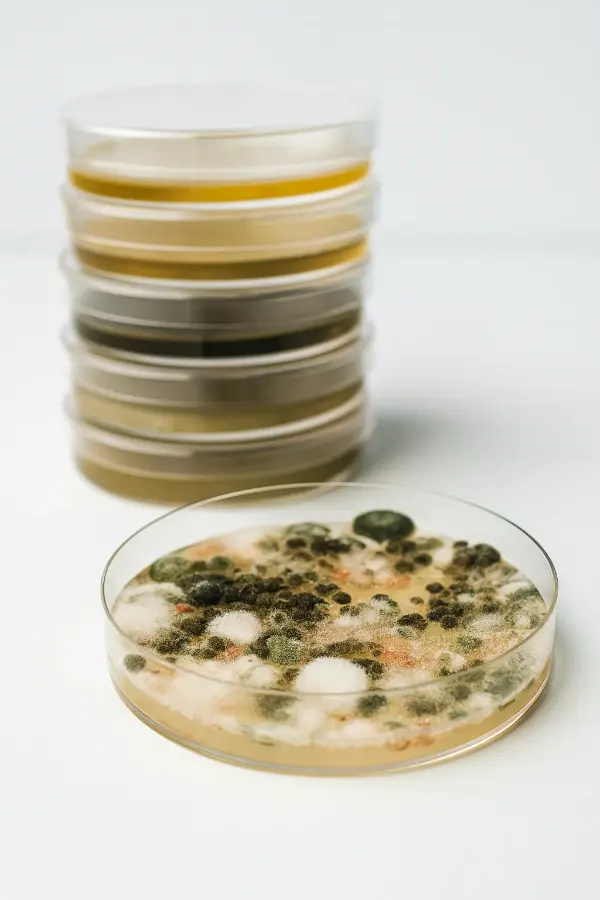
Nahaufnahme einer Petrischale mit grünem und weißem Schimmel, im Hintergrund ein Stapel weiterer Petrischalen.

Schimmelpilz & Wasserschaden
Desinfektion bei Schimmelpilzen / Wasserschäden
Medizin & Pflege
Desinfektion von Oberflächen im Medizin- und Pflegebereich
Raumpflege & Hygiene
Flächendesinfektion in der Raumpflege
Pharma & Labor (GMP)
Flächendesinfektion in Bio-Labors und GMP-Räumen
Lebensmittelindustrie
Flächendesinfektion in der Lebens- und Futtermittelproduktion
Stalldesinfektion
Flächendesinfektion in Tierstallungen
Schimmelpilz & Wasserschaden
Desinfektion bei Schimmelpilzen / Wasserschäden
Sanosil Desinfektionsmittel für die Schimmelpilz- & Wasserschadensanierung
Schimmelpilze sind ein bedeutender Bestandteil des natürlichen biologischen Kreislaufs. Sie übernehmen eine wichtige Funktion beim Abbau organischer Materialien und sorgen so für die erneute Verfügbarkeit von Mineralien und Nährstoffen. Leider können einige Schimmelpilze durch die Bildung von Giftstoffen oder die Freisetzung von Sporen in der Luft gesundheitliche Beeinträchtigungen verursachen. Daher ist das Wachstum von Schimmelpilzen in Innenräumen aus hygienischer Sicht nicht akzeptabel.
Besonders schnell entwickeln sich Schimmelpilze bei hoher Material- und Luftfeuchtigkeit – typische Folgen von Wasserschäden. Sanosil-Desinfektionsmittel haben sich über Jahre hinweg als zuverlässige Lösung zur Sanierung von Feuchte- und Schimmelpilzschäden bewährt. Die Formulierung mit geboostetem Wasserstoffperoxid macht diese Produkte sowohl für gewerbliche als auch für private Anwender zur bevorzugten Wahl.
Sanosil Desinfektionsmittel für die Schimmelpilzbekämpfung & Wasserschadensanierung: eine gute Wahl
- hochwirksam gegen Schimmelpilze, Fäkal- und Nasskeime
- reduziert Modergeruch, Schimmelpilzgifte und Allergien auslösende Schimmelpilz- Oberflächenproteine durch Oxidation
- mit geboostetem Wasserstoffperoxid
- Wasserstoffperoxid zerfällt zu Wasser und Sauerstoff
- einfache und sichere Anwendung – Gebrauchsfertig, kein ADR
- für gewerbliche und private Anwender
Geeignete Sanosil-Produkte zur Schimmelpilz – & Wasserschadensanierung

Sanosil S010
Der Klassiker: Schimmelbekämpfungs-mittel mit Depoteffekt
- bewährte Wirksamkeit gegen Bakterien, Viren, Hefen, Pilze / Schimmelpilze und Sporen
- Wasserstoffperoxid baut sich zu Wasser und Sauerstoff ab – hinterlässt keine übelriechende Dämpfe
- Depoteffekt- ideal bei feuchten Materialien
- Reduziert durch Oxidation Schimmelpilzgifte, Allergene und Modergeruch

Sanosil SD7
Gebrauchsfertiges, sporozides Desinfektionsmittel mit sehr rascher Wirkung für Oberflächen mit erhöhten Hygieneanforderungen
- schnelle Wirkung gegen Bakterien, Hefen, Pilze, behüllte Viren (inkl. Noroviren) und Sporen
- einfache und sichere Anwendung (ready to use), aufschäumbar für ärosolfreies Sprühen
- hervorragende Netzwirkung auf allen Oberflächen
- mit synergistisch verstärktem Wasserstoffperoxid (H2O2 zerfällt zu Wasser und Sauerstoff)
Schimmelpilzwachstum nach einem Wasserschaden: warum?
Ein Wasserschaden bezeichnet die Beeinträchtigung oder Zerstörung von Materialien durch das Eindringen von Wasser. Zu den häufigsten Ursachen zählen Hochwasser, ein Rückstau in Abwasserleitungen, Rohrbrüche oder eindringendes Löschwasser nach einem Brand. Ebenso können schleichende Durchfeuchtungen der Bausubstanz auftreten, beispielsweise ausgelöst durch undichte Wasser- oder Heizungsleitungen.
Neben den direkten Materialschäden führt das eingedrungene Wasser zu anhaltend hoher Luft- und Materialfeuchtigkeit. Dadurch entstehen ideale Voraussetzungen für das schnelle Wachstum von Pilzen und Nasskeimen, die sich auf feuchten Untergründen mit organischen Nährstoffen besonders gut entwickeln.

Keimbekämpfung zur Unterstützung der Trocknungsmassnahmen
Gerade bei Fäkalwasserschäden besteht das Risiko, dass die betroffenen Flächen stark mit gesundheitsgefährdenden Keimen verunreinigt sind. Werden in solchen Situationen unbedacht Trocknungsmassnahmen wie das Einblasen von Trockenluft gestartet, können Darm- und Fäkalkeime über Aerosole aufgewirbelt und anschliessend eingeatmet werden. Abhängig von der Widerstandsfähigkeit und dem krankmachenden Potential der Erreger können solche belasteten Aerosole Infektionen und teils schwere Magen-Darm-Beschwerden auslösen.
Der gezielte Einsatz eines geeigneten Desinfektionsmittels zur Dekontamination kritischer Bereiche ist daher essenziell, um die Gesundheit von Mitarbeitenden und Raumnutzenden bestmöglich zu schützen. Zudem verhindert eine frühzeitig durchgeführte Desinfektion durchnässter Oberflächen die schnelle Bildung von Schimmelpilzen, sodass wertvolle Zeit gewonnen wird, bis die Trocknungsarbeiten abgeschlossen sind. Sanosil Desinfektionsmittel haben sich für die Behandlung auch stark kontaminierter Oberflächen bis heute hervorragend bewährt.

Applikations- und Anwendungsmethoden für die Desinfektion bei Wasserschäden
- Direktes Sprühen mit dem Drucksprühgerät
Bei dieser Methode wird das Desinfektionsmittel mit einem Drucksprühgerät direkt auf die zu behandelnden Stellen aufgetragen. Besonders geeignet ist dafür Sanosil SD7, das sich mit einem passenden Sprühkopf zu einem stabilen Schaum aufschäumen lässt. Der aufgebrachte Schaum kann nahezu ohne Aerosolbildung appliziert werden und ermöglicht gleichzeitig eine ausgezeichnete visuelle Kontrolle darüber, welche Bereiche bereits behandelt wurden und welche noch nicht. - Direktes Sprühen mit einem ULV-Sprühgerät
Ein Turbinen-ULV erzeugt einen feinen, gerichteten Sprühnebel mit einer Reichweite von mehreren Metern. Dadurch können auch grössere Oberflächen schnell und effizient desinfiziert werden. Obwohl Sanosil Desinfektionsmittel nach der Anwendung nahezu vollständig zu Wasser und Sauerstoff zerfallen, können die bei dieser Methode entstehenden Aerosole Augen und Atemwege reizen. Aus diesem Grund ist diese Anwendung ausschliesslich für gewerbliche Nutzer geeignet, die über die notwendige professionelle Schutzausrüstung verfügen.

- Wischapplikation / Auftrag mit Malerrolle
Bei dieser Methode wird das Desinfektionsmittel gezielt und völlig aerosolfrei mit einem Mop, einem Lappen oder einer Malerrolle aufgetragen. Sie eignet sich besonders für kleinere Flächen, gut zugängliche Bereiche sowie glatte und nicht saugfähige Oberflächen. - Hohlräume ausschäumen
Für schwer erreichbare Bereiche und Hohlräume – etwa Bodenkonstruktionen mit eingedrungenem Wasser, Einbaumöbel mit verdecktem Schimmelpilzbefall oder Kabelkanäle – bietet sich die Schaumanwendung an. Dabei wird das Desinfektionsmittel mit einem Schaumkonzentrat (Sanosil SFS) gemischt und mittels Schaumgenerator in die entsprechenden Hohlräume eingebracht. Der gebildete Schaum bekämpft Schimmelpilze zuverlässig und fixiert das abgestorbene Material auf den Oberflächen. Anschliessend wird die Feuchtigkeit mittels Trocknungsluft aus dem Bereich entfernt.

- Schimmelsporen-Bekämpfung in der Luft durch Aerosoldesinfektion
Auch nach einer erfolgreichen Wasserschadensanierung sowie der Desinfektion und Entfernung allfälliger Schimmelpilzrasen kann die Raumluft weiterhin unterschiedlich stark mit Schimmelsporen oder anderen Mikroorganismen belastet sein. Soll der gesamte Rauminhalt inklusive der Luft desinfiziert werden, ist der Einsatz eines speziellen Aerosolgeräts wie dem Sanosil C10 oder CT-20 erforderlich – kombiniert mit einem geeigneten Desinfektionsmittel wie Sanosil S015 oder Q-Dis 8.
Eine solche umfassende Aerosoldesinfektion eines ganzen Raumes erfordert fachliches Know-how und darf ausschliesslich von gewerblichen Anwendern in klar abgegrenzten bzw. abgeschotteten Gebäudebereichen durchgeführt werden.



